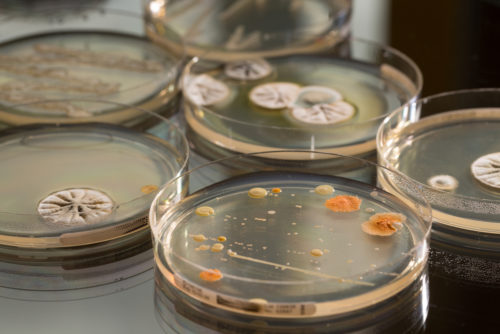

Régénérateurs de sols
Activation du sol
Cette gamme de régénérateurs et activateurs de sols est tout particulièrement destinée aux espaces verts, et terrains à gazon naturel, tant pour leurs propriétés racinaires que pour leur forme adaptée à un épandage homogène et facile.
Constitués de différentes bactéries, champignons et levures, nos préparations de micro-organismes et de mycelliums utiles « Green-Bact » augmentent l’interaction entre la plante et le sol avec pour objectif de réduire la pression d’infection et de favoriser l’enracinement.
Nous développons également d’autres spécialités à base d’argile absorbante et d’algues sélectionnées, dont il a été démontré que les molécules viennent stimuler efficacement les enzymes de défense de la plante et les bactéries du sol, facilitant ainsi l’absorption des minéraux
Formes et conditionnements
- Green-Bact : Bag In Box de 20 L sur palettes de 960 L
- Amendements algués nutritifs : sacs de 20 à 25 kg sur palette d’1 tonne (micro-granulés)
Avantages produits et bénéfices
- Colonisation rapide et efficace des souches utiles apportées
- Dégradation active de la matière organique (contre les problèmes de feutre)
- Développe considérablement les systèmes racinaires des graminées
- Stoppe les proliférations microbiennes néfastes (Fusarium, Pénecillium, Cladosporium)
- Capte l’azote aérien et l’azote soluble (sujet au lessivage)
- Améliore la perméabilité à l’eau et à l’air du sol
- Utilisable en agriculture biologique